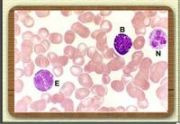

文件列表
来自医学百科
本特殊页面展示所有上传的文件。
| 日期 | 名称 | 缩略图 | 尺寸 | 用户 | 说明 | 版本 |
|---|---|---|---|---|---|---|
| 2014年1月17日 (五) 23:33 | Bk7tu.jpg (文件) |  |
27 KB | Admin | 1 | |
| 2014年1月17日 (五) 23:33 | Gunq9zmu.jpg (文件) |  |
37 KB | Admin | 1 | |
| 2014年1月17日 (五) 23:33 | Bk9mg.jpg (文件) |  |
98 KB | Admin | 1 | |
| 2014年1月17日 (五) 23:33 | Gkpiclbn.jpg (文件) |  |
24 KB | Admin | 1 | |
| 2014年1月17日 (五) 23:33 | Bkb5w.jpg (文件) |  |
214 KB | Admin | 1 | |
| 2014年1月17日 (五) 23:32 | Guwhhlsw.jpg (文件) |  |
20 KB | Admin | 1 | |
| 2014年1月17日 (五) 23:32 | Bk2qn.jpg (文件) |  |
145 KB | Admin | 1 | |
| 2014年1月17日 (五) 23:32 | Bk2in.jpg (文件) |  |
130 KB | Admin | 1 | |
| 2014年1月17日 (五) 23:32 | Bk6tg.jpg (文件) |  |
4 KB | Admin | 1 | |
| 2014年1月17日 (五) 23:32 | Goqr3gu8.jpg (文件) |  |
10 KB | Admin | 1 | |
| 2014年1月17日 (五) 23:32 | Bkbkt.jpg (文件) |  |
34 KB | Admin | 1 | |
| 2014年1月17日 (五) 23:32 | Bk0gd.jpg (文件) |  |
4 KB | Admin | 1 | |
| 2014年1月17日 (五) 23:32 | Bkba9.jpg (文件) |  |
70 KB | Admin | 1 | |
| 2014年1月17日 (五) 23:32 | Glz4r4wj.jpg (文件) |  |
43 KB | Admin | 1 | |
| 2014年1月17日 (五) 23:32 | Bkqtq.jpg (文件) |  |
143 KB | Admin | 1 | |
| 2014年1月17日 (五) 23:32 | Guwgh5ns.jpg (文件) |  |
3 KB | Admin | 1 | |
| 2014年1月17日 (五) 23:32 | Bk5o9.jpg (文件) |  |
18 KB | Admin | 1 | |
| 2014年1月17日 (五) 23:31 | Bkpmy.jpg (文件) |  |
11 KB | Admin | 1 | |
| 2014年1月17日 (五) 23:31 | Bkbp7.jpg (文件) |  |
7 KB | Admin | 1 | |
| 2014年1月17日 (五) 23:31 | Gv7sg11i.jpg (文件) |  |
13 KB | Admin | 1 | |
| 2014年1月17日 (五) 23:31 | Bkn7a.jpg (文件) |  |
15 KB | Admin | 1 | |
| 2014年1月17日 (五) 23:31 | Bk1iu.jpg (文件) |  |
99 KB | Admin | 1 | |
| 2014年1月17日 (五) 23:31 | Bkd0v.jpg (文件) |  |
57 KB | Admin | 1 | |
| 2014年1月17日 (五) 23:31 | Gldn4jyr.jpg (文件) |  |
10 KB | Admin | 1 | |
| 2014年1月17日 (五) 23:31 | Bkjy8.jpg (文件) |  |
130 KB | Admin | 1 | |
| 2014年1月17日 (五) 23:31 | Ex说得多ample.jpg (文件) |  |
23 KB | Admin | 1 | |
| 2014年1月17日 (五) 23:31 | Bki79.jpg (文件) |  |
13 KB | Admin | 1 | |
| 2014年1月17日 (五) 23:31 | Gl0x1pnp.jpg (文件) |  |
8 KB | Admin | 1 | |
| 2014年1月17日 (五) 23:31 | Bkfan.jpg (文件) |  |
15 KB | Admin | 1 | |
| 2014年1月17日 (五) 23:30 | Gum5odb6.jpg (文件) | 2 KB | Admin | 1 | ||
| 2014年1月17日 (五) 23:30 | Bk9ta.jpg (文件) |  |
26 KB | Admin | 1 | |
| 2014年1月17日 (五) 23:30 | Gkkw4k9y.gif (文件) |  |
31 KB | Admin | 1 | |
| 2014年1月17日 (五) 23:30 | Bkfia.jpg (文件) |  |
17 KB | Admin | 1 | |
| 2014年1月17日 (五) 23:30 | Gq0ra62s.jpg (文件) |  |
26 KB | Admin | 1 | |
| 2014年1月17日 (五) 23:30 | Bkm9m.jpg (文件) |  |
4 KB | Admin | 1 | |
| 2014年1月17日 (五) 23:30 | Bknfh.jpg (文件) |  |
7 KB | Admin | 1 | |
| 2014年1月17日 (五) 23:30 | Bkb82.jpg (文件) |  |
12 KB | Admin | 1 | |
| 2014年1月17日 (五) 23:30 | Glf56cww.jpg (文件) | 3 KB | Admin | 1 | ||
| 2014年1月17日 (五) 23:30 | Bklxd.jpg (文件) |  |
33 KB | Admin | 1 | |
| 2014年1月17日 (五) 23:30 | Guwf0raj.jpg (文件) |  |
8 KB | Admin | 1 | |
| 2014年1月17日 (五) 23:30 | Bkchi.jpg (文件) |  |
11 KB | Admin | 1 | |
| 2014年1月17日 (五) 23:29 | Jiatingyixuebaike zijiuhujiu088.jpg (文件) |  |
4 KB | Admin | 1 | |
| 2014年1月17日 (五) 23:29 | Bkjtj.jpg (文件) |  |
133 KB | Admin | 1 | |
| 2014年1月17日 (五) 23:29 | Gnsnq6pm.jpg (文件) |  |
14 KB | Admin | 1 | |
| 2014年1月17日 (五) 23:29 | Bkb7b.jpg (文件) |  |
6 KB | Admin | 1 | |
| 2014年1月17日 (五) 23:29 | Bk9pw.jpg (文件) | |
7 KB | Admin | 1 | |
| 2014年1月17日 (五) 23:29 | Bkca0.jpg (文件) |  |
136 KB | Admin | 1 | |
| 2014年1月17日 (五) 23:29 | Gpzfusbp.jpg (文件) |  |
19 KB | Admin | 1 | |
| 2014年1月17日 (五) 23:29 | Bk26s.jpg (文件) |  |
19 KB | Admin | 1 | |
| 2014年1月17日 (五) 23:29 | Bk25q.jpg (文件) |  |
10 KB | Admin | 1 |